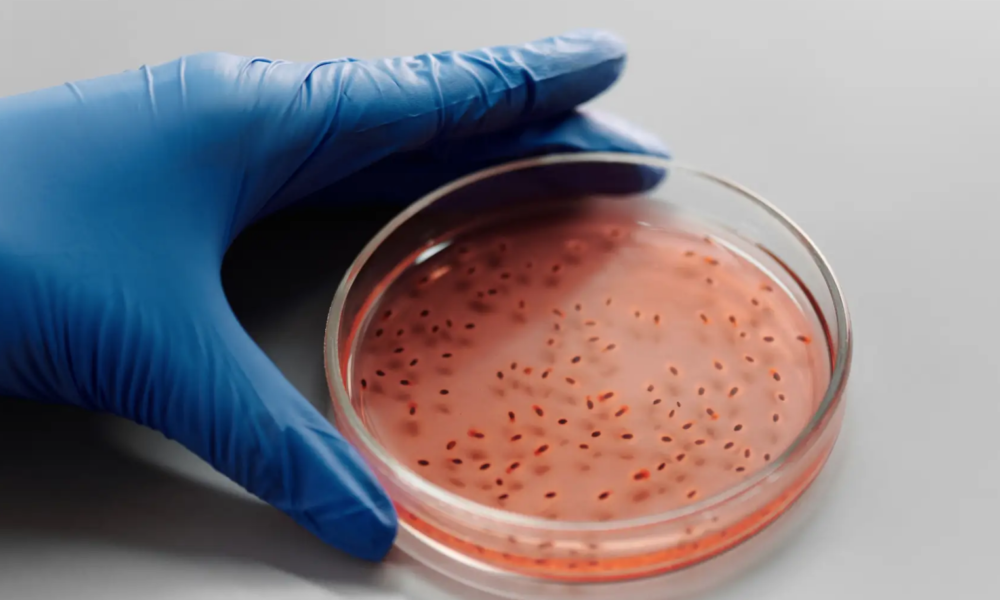
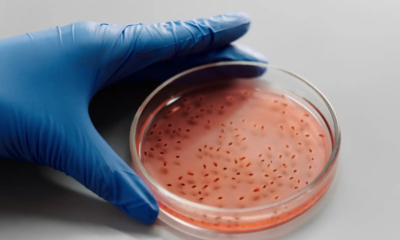
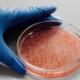

Expertos en vacunas de la Organización Mundial de la Salud (OMS) recomendaron hoy que las vacunas de refuerzo contra el Covid-19 ya no sean administradas para...



Al menos tres personas murieron en Estados Unidos, derivado del uso de gotas oftálmicas contaminadas con una bacteria resistente a los medicamentos. Los Centros para el...

Un hongo mortal resistente a los medicamentos que se extendió por los Estados Unidos experimentó un aumento dramático en los casos durante la pandemia de COVID-19,...



El presidente Andrés Manuel López Obrador pidió evaluar la posibilidad de sustituir el uso de fentanilo médico, que se receta para mitigar dolores intensos, con otros...



A ya tres años de la pandemia de COVID-19, expertos de todo el mundo aún se siguen preguntando cómo empezó y dónde se originó esta clase...



Con la sexta ola de COVID ya de salida en México, los casos se han ido reduciendo de manera lenta a comparación de las primeras semanas...



El Congreso estadounidense aprobó este viernes un proyecto de ley que solicita a la directora nacional de Inteligencia, Avril Haines, desclasificar la información relativa al origen...



Cada año aproximadamente 300 mil mujeres mueren por cáncer cervicouterino, siendo esta la quinta causa de muerte de mujeres en todo el mundo. A pesar de...



En el condado de Charlotte, Florida, un hombre murió tras lavarse la nariz con agua de la llave, siendo víctima de una ameba “comecerebro”. A través...



México llegó al Día Mundial de la Obesidad como uno de los líderes en sobrepeso a nivel mundial y con un panorama todavía sombrío para reducir...